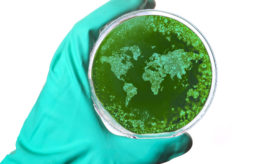

ΕΟΔΥ: Σε τροχιά υλοποίησης νέος ψηφιακός μηχανισμός επιδημιολογικής επιτήρησης
Το νέο σύστημα θα επιτρέπει συλλογή και ανάλυση επιδημιολογικών δεδομένων σε πραγματικό χρόνο, με χρήση προηγμένων ψηφιακών εργαλείων και...

Το νέο σύστημα θα επιτρέπει συλλογή και ανάλυση επιδημιολογικών δεδομένων σε πραγματικό χρόνο, με χρήση προηγμένων ψηφιακών εργαλείων και...

Η παγκόσμια κοινότητα βρίσκεται αντιμέτωπη με μια σοβαρή ανατροπή, καθώς ασθένειες και επιδημίες που θεωρούνταν σχεδόν εξαφανισμένες επιστρέφουν απειλητικά....

Σε σκύλους ρακούν, βιζόν και άλλα ζώα που εκτρέφονται για τη γούνα τους στην Κίνα, στην πρώτη σε βάθος...

Τι συμβαίνει στην Ευρωπαϊκή Ένωση και στον υπόλοιπο κόσμο

Στόχος να μη χαθεί η πρόοδος που σημειώθηκε την περίοδο της πανδημίας σε επίπεδο γονιδιωματικής επιτήρησης
Ο κόσμος εισέρχεται σε μια «νέα φάση» στην οποία οι μεγάλες επιδημίες θανατηφόρων ασθενειών, όπως αυτή του ιού Έμπολα,...

Οι μικροοργανισμοί που επί δεκαετίες παρέμεναν ουσιαστικά άγνωστοι, αποτελώντας το «φόβητρο» επιστημόνων και ασθενών, σήμερα αποκαλύπτουν μια άλλη πλευρά...

Διάφορα κράτη, ΜΚΟ και φαρμακευτικές εταιρείες ξεκίνησαν σήμερα μια πρωτοβουλία στο Νταβός, στο περιθώριο του Παγκόσμιου Οικονομικού Φόρουμ που...

Για πέντε ασθένειες που έχουν τη δυναμική επιδημίας μέσα στο 2016 εφιστά την προσοχή η διεθνής ανθρωπιστική οργάνωση Γιατροί...

Μια δυσμενέστατη πρόβλεψη για το πως θα εξελιχθεί η υγεία των Ελλήνων στο μέλλον κάνουν οι νοσοκομειακοί γιατροί (ΟΕΝΓΕ)....

Πως μπορεί μια μαθηματική πράξη, ένας αλγόριθμος να έχει εφαρμογή στον εντοπισμό μιας επιδημίας; Ένας Πορτογάλος ερευνητής της Πολυτεχνικής...